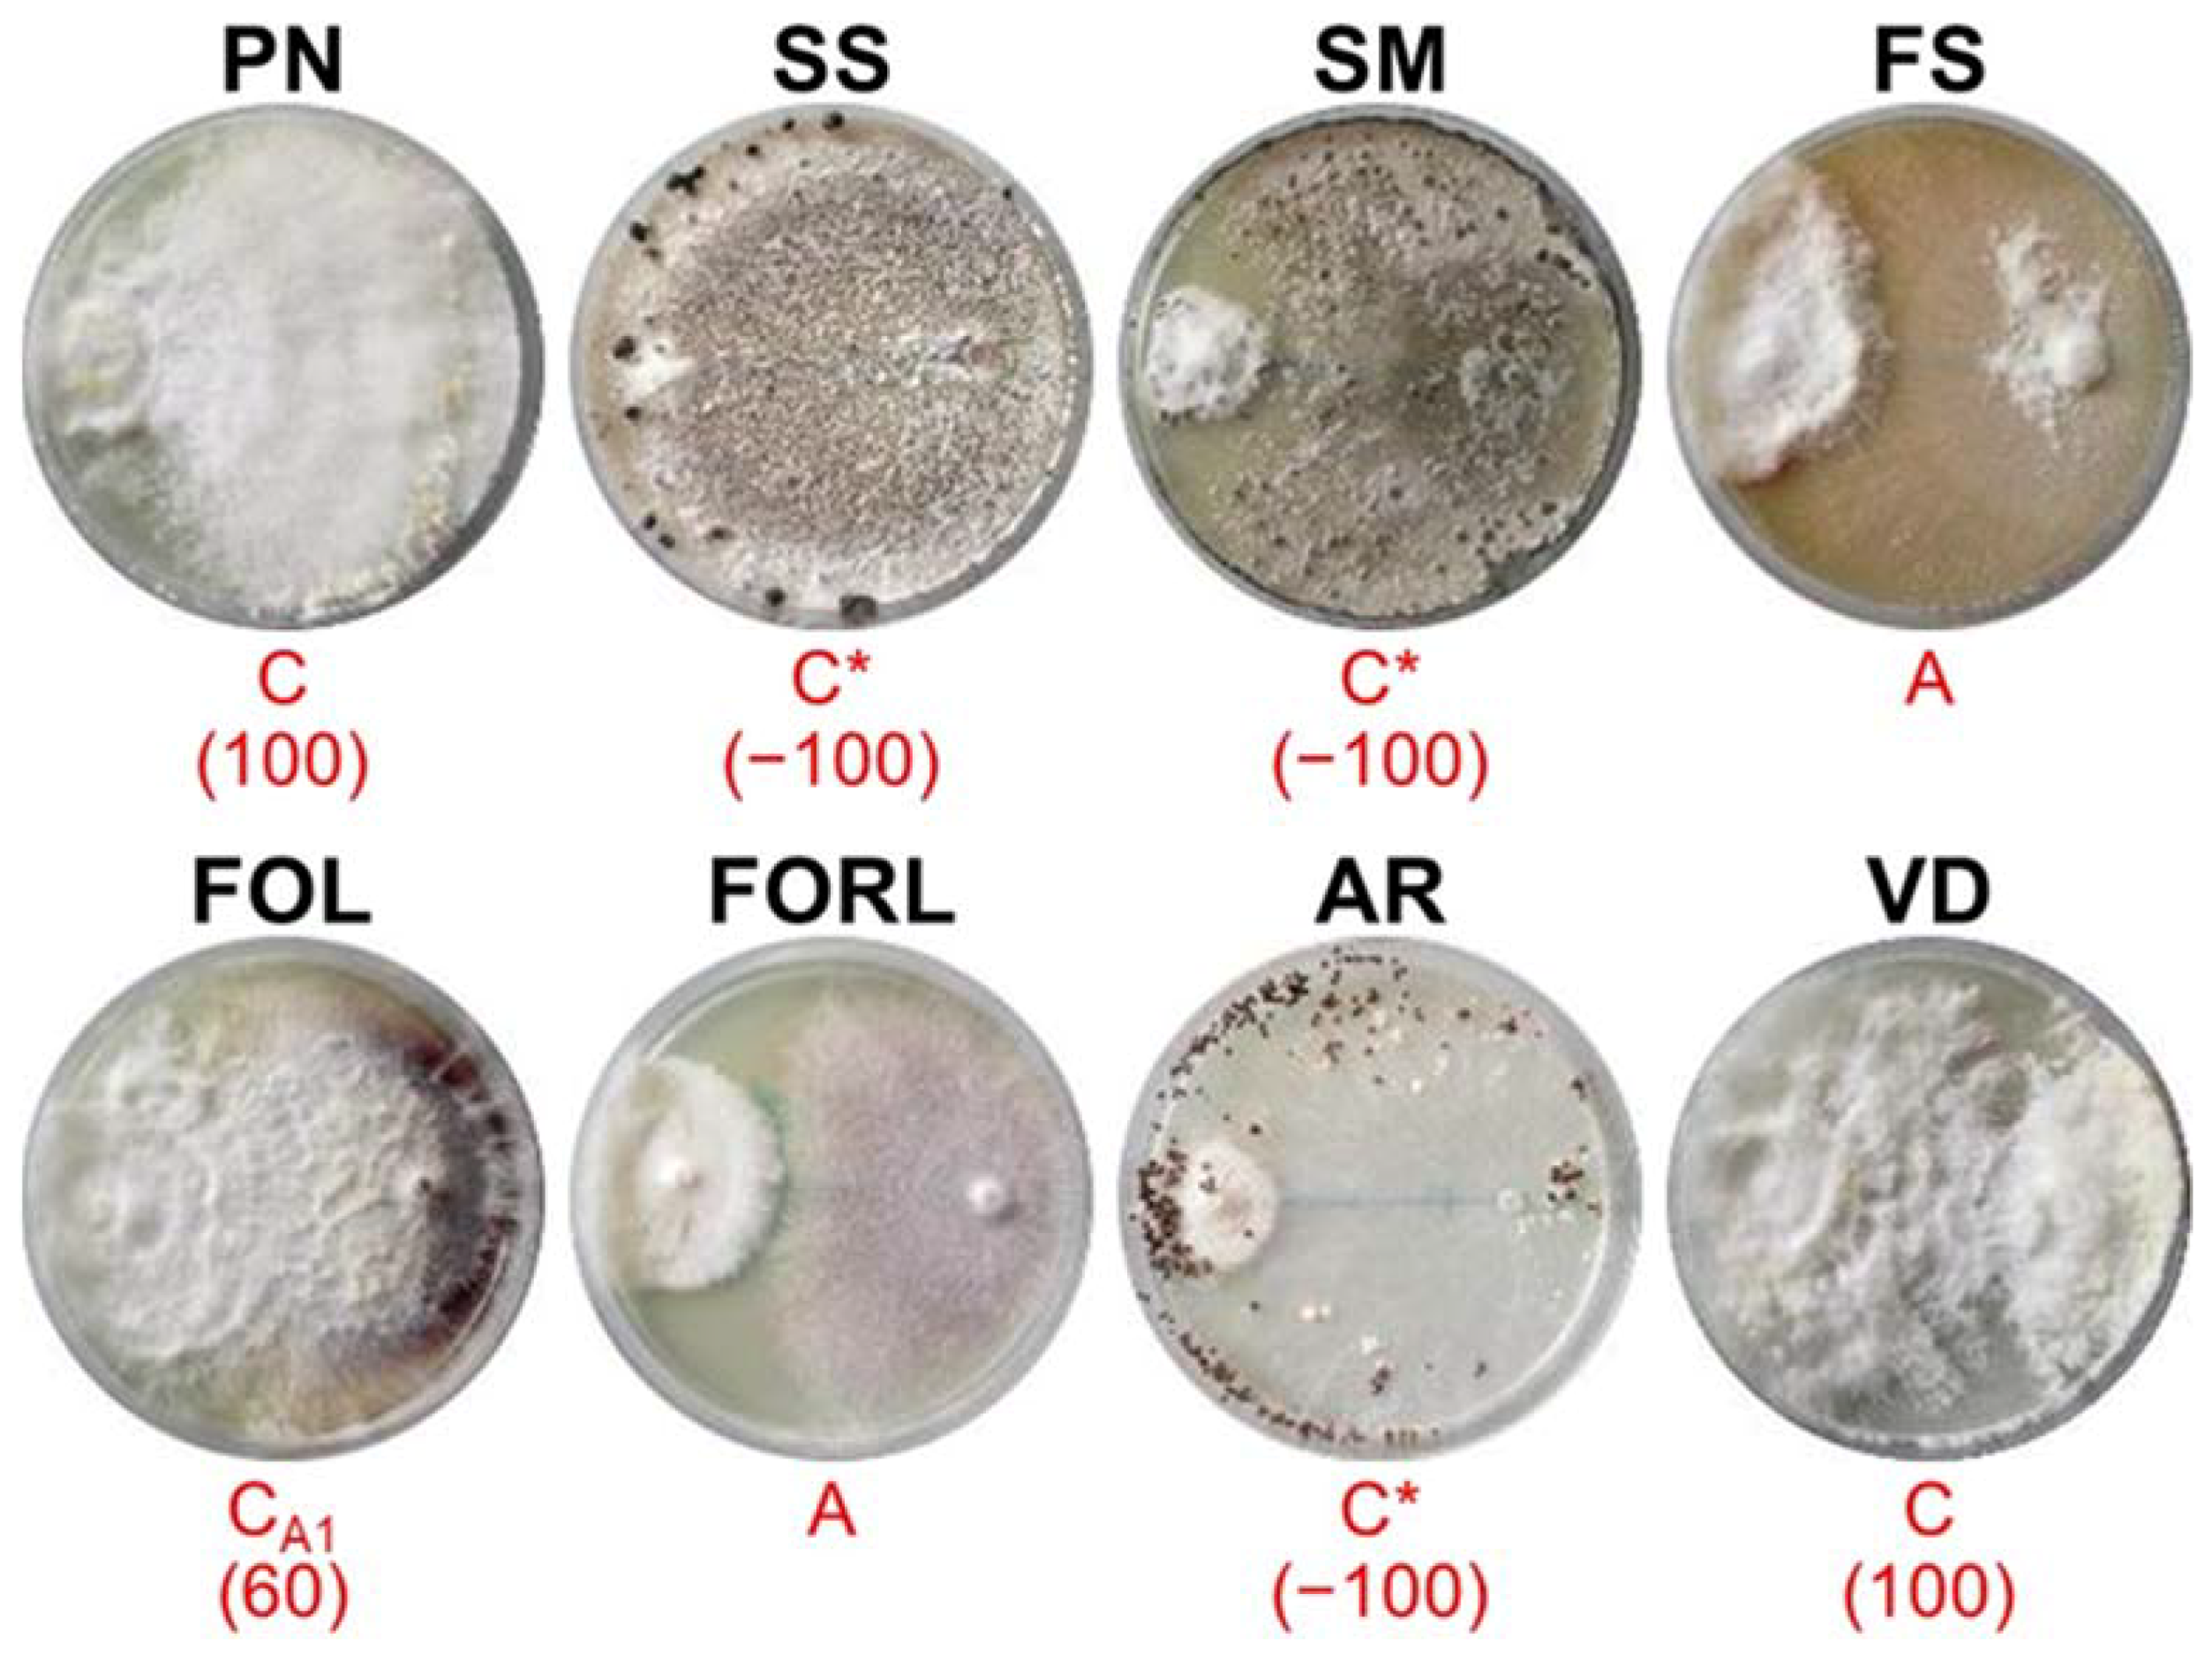
Sustainability 14 02693 g004 Sustainability 14 02693 g004

In Vitro Screening of New Biological Limiters against Some of the Main Soil-Borne Phytopathogens
Abstract
1. Introduction
2. Materials and Methods
2.1. Strains and Media
2.2. Growth Rate
2.3. In Vitro Dual Culture Bioassays
2.4. Statistical Analysis
3. Results
3.1. Growth Rate
3.2. In Vitro Dual Culture Bioassays
4. Discussion
5. Conclusions and Future Trend
Author Contributions
Funding
Institutional Review Board Statement
Informed Consent Statement
Data Availability Statement
Acknowledgments
Conflicts of Interest
References
- Rizzo, D.M.; Lichtveld, M.; Mazet, J.A.K.; Togami, E.; Miller, S.A. Plant health and its effects on food safety and security in a One Health framework: Four case studies. One Health Outlook 2021, 3, 6. [Google Scholar] [CrossRef] [PubMed]
- Thambugala, K.M.; Daranagama, D.A.; Phillips, A.J.L.; Kannangara, S.D.; Promputtha, I. Fungi vs. fungi in biocontrol: An overview of fungal antagonists applied against fungal plant pathogens. Front. Cell. Infect. Microbiol. 2020, 10, 604923. [Google Scholar] [CrossRef] [PubMed]
- Strange, R.N.; Scott, P.R. Plant disease: A threat to global food security. Ann. Rev. Phytopathol. 2005, 43, 83–116. [Google Scholar] [CrossRef]
- Agrios, G.N. Plant Pathology, 5th ed.; Elsevier Academic Press: San Diego, CA, USA, 2005; p. 992. [Google Scholar]
- Kuhn, D.M.; Ghannoum, M.A. Indoor Mold, Toxigenic Fungi, and Stachybotrys chartarum: Infectious disease perspective. Clin. Microbiol. Rev. 2003, 16, 144–172. [Google Scholar] [CrossRef] [PubMed]
- Singh, V.K.; Chawla, S. Cultural Practices: An eco-friendly innovative approaches in plant disease management. In Eco-Friendly Innovative Approaches in Plant Disease Management; Singh, V.K., Singh, Y., Singh, A., Eds.; International Book Publisher: Dehradun, India, 2012; pp. 1–20. [Google Scholar]
- Haq, I.U.; Ijaz, S. Plant Disease Management Strategies for Sustainable Agriculture through Traditional and Modern Approaches Series. Volume 13: Sustainability in Plant and Crop Protection; Springer Nature: Cham, Switzerland, 2020; p. 339. [Google Scholar]
- Ramakrishnan, B.; Venkateswarlu, K.; Sethunathan, N.; Megharaj, M. Local applications but global implications: Can pesticides drive microorganisms to develop antimicrobial resistance? Sci. Total Environ. 2019, 654, 177–189. [Google Scholar] [CrossRef]
- Fisher, M.C.; Hawkins, N.J.; Sanglard, D.; Gurr, S.J. Worldwide emergence of resistance to antifungal drugs challenges human health and food security. Science 2018, 360, 739–742. [Google Scholar] [CrossRef]
- Nega, A. Review on Concepts in Biological Control of Plant Pathogens. J. Biol. Agric. Health. 2014, 4, 33–55. [Google Scholar]
- Pal, K.K.; McSpadden Gardener, B. Biological Control of Plant Pathogens. Plant Health Inst. 2006, 10, 1117–1122. [Google Scholar] [CrossRef]
- Andrews, J.H. Biological control in the phyllosphere. Ann. Rev. Phytopathol. 1992, 30, 603–635. [Google Scholar] [CrossRef]
- Stirling, M.; Stirling, G. Disease Management: Biological Control. In Plant Pathogens and Plant Diseases; Brown, J., Ogle, H., Eds.; Rockvale Publications: Armidale, Australia, 1997; pp. 427–439. [Google Scholar]
- Baker, K.F. Evolving concepts of biological control of plant pathogens. Ann. Rev. Phytopathol. 1987, 25, 67–85. [Google Scholar] [CrossRef]
- Bubici, G. Streptomyces spp. as biocontrol agents against Fusarium species. CAB Rev. 2018, 13, 050. [Google Scholar] [CrossRef]
- Toussoun, T.A.; Nelson, P.E. A Pictorial Guide to the Identification of Fusarium Species according to the Taxonomic System of Snyder and Hansen; Pennsylvania State University Press: London, UK, 1968; p. 51. [Google Scholar]
- Badalyan, S.M.; Innocenti, G.; Garibyan, N.G. Antagonistic activity of xylotrophic mushrooms against pathogenic fungi of cereals in dual culture. Phytopathol. Mediterr. 2002, 41, 200–225. [Google Scholar] [CrossRef]
- Badalyan, S.M.; Innocenti, G.; Garibyan, N.G. Interactions between xylotrophic mushrooms and mycoparasitic fungi in dual culture. Phytopathol. Mediterr. 2004, 43, 44–48. [Google Scholar] [CrossRef]
- Katan, J. Interactions of soilborne pathogens with roots and aboveground plant organs. In Plant Roots: The Hidden Half, 3rd ed.; Waisel, Y., Eshel, A., Kafkafi, U., Eds.; Basel Marcel Dekker Inc.: New York, NY, USA, 2002; pp. 949–959. [Google Scholar]
- Martin, F.N. Development of alternative strategies for management of soilborne pathogens currently controlled with methyl bromide. Annu. Rev. Phytopathol. 2003, 41, 325–350. [Google Scholar] [CrossRef]
- Kiss, L. How dangerous is the use of fungal biocontrol agents to nontarget organisms? New Phytol. 2004, 163, 453–455. [Google Scholar] [CrossRef]
- Whipps, J.M.; Lumsden, R.D. Commercial use of fungi as plant disease biological control agents: Status and prospects. In Fungi as Biocontrol Agents: Progress, Problems and Potential; Butt, T.M., Jackson, C., Magan, N., Eds.; CABI Publishing: Wallingford, UK, 2001; pp. 9–22. [Google Scholar]
- Klokočar-Šmit, Z.D.; Lević, J.T.; Maširević, S.N.; Grozdanović-Varga, J.M.; Vasić, M.A.; Aleksić, S.R. Fusarium rot of onion and possible use of bioproduct. Proc. Matica Srp. Nat. Sci. 2008, 114, 135–148. [Google Scholar] [CrossRef]
- Lo, C.T. General mechanisms of action of microbial biocontrol agents. Plant Pathol. Bul. 1998, 7, 155–166. [Google Scholar]
- Milgroom, M.G.; Cortesi, P. Biological control of chestnut blight with hypovirulence: A critical analysis. Ann. Rev. Phytopathol. 2004, 42, 311–338. [Google Scholar] [CrossRef]
- Islam, T.M.; Hashidoko, Y.; Deora, A.; Ito, T.; Tahara, S. Suppression of damping-off disease in host plants by the rhizoplane bacterium Lysobacter sp. strain SB-K88 is linked to plant colonization and antibiosis against soilborne peronosporomycetes. Appl. Environ. Microb. 2005, 71, 3786–3796. [Google Scholar] [CrossRef]
- Benhamou, N.; Chet, I. Cellular and molecular mechanisms involved in the intersection between Trichoderma harzianum and Pythium ultimum. Appl. Environ. Microb. 1997, 63, 2095–2099. [Google Scholar] [CrossRef]
- Kloepper, J.W.; Ryu, C.M.; Zhang, S. Induce systemic resistance and promotion of plant growth by Bacillus spp. Phytopathology 2004, 94, 1259–1266. [Google Scholar] [CrossRef] [PubMed]
- Kilic-Ekici, O.; Yuen, G.Y. Induced resistance as a mechanism of biological control by Lysobacter enzymogenes strain C3. Phytopathology 2003, 93, 1103–1110. [Google Scholar] [CrossRef] [PubMed][Green Version]
- Wilhite, S.E.; Lunsden, R.D.; Strancy, D.C. Peptide synthetase gene in Trichoderma virens. Appl. Environ. Microbiol. 2001, 67, 5055–5062. [Google Scholar] [CrossRef] [PubMed]
- Menzler-Hokkanen, I. Socioeconomic significance of biological control. In An Ecological and Societal Approach to Biological Control; Eilenbergh, J., Hokkanen, M.T., Eds.; Springer: Dordrecht, The Netherlands, 2006; pp. 13–25. [Google Scholar]
- He, P.; Chintamanani, S.; Chen, Z.; Zhu, L.; Kunkel, B.N.; Alfano, J.R.; Tang, X.; Zhou, J.M. Activation of a COI1-dependent pathway in Arabidopsis by Pseudomonas syringae type III effectors and coronatine. Plant J. 2004, 37, 589–602. [Google Scholar] [CrossRef]
- Raaijmakers, J.M.; Vlami, M.; De Souza, J.T. Antibiotic production by bacterial biocontrol agents. Antonie Van Leeuwenhoek 2002, 81, 537–547. [Google Scholar] [CrossRef]
- Kunz, C.; Sellam, O.; Bertheau, Y. Purification and characterization of a chitinase from the hyperparasitic fungus Aphanocladium album. Physiol. Mol. Plant Pathol. 1992, 40, 117–131. [Google Scholar] [CrossRef]
- Biali, M.; Dinoor, A.; Eshed, N.; Kenneth, R. Aphanocladium album, a fungus inducing teliospore production in rusts. Ann. Appl. Biol. 1972, 72, 37–42. [Google Scholar] [CrossRef]
- Ciccarese, F.; Longo, O.; Ambrico, A.; Schiavone, D. Aphanocladium album: Un promettente limitatore biologico dell’oidio del pomodoro e dello zucchino. La difesa delle colture in agricoltura biologica. Not. Mal. Piante 2001, 52, 69–71. [Google Scholar]
- Ciccarese, F.; Amenduni, M.; Schiavone, D.; Ambrico, A. Aphanocladium album, a new promising biocontrol agent against Oidium lycopersici. In Proceedings of the 10th Congress of the Mediterranean Phytopathological Union, Montpellier, France, 1–5 June 1997; pp. 559–562. [Google Scholar]
- Sasanelli, N.; Ciccarese, F.; Papajová, I. Aphanocladium album by via sub-irrigation in the control of Pyrenochaeta lycopersici and Meloidogyne incognita on tomato in a plastic-house. Helminthologia 2008, 45, 137–142. [Google Scholar] [CrossRef]
- Leoni, C.; Piancone, E.; Sasanelli, N.; Bruno, G.L.; Manzari, C.; Pesole, G.; Ceci, L.R.; Volpicella, M. Plant Health and Rhizosphere Microbiome: Effects of the Bionematicide Aphanocladium album in Tomato Plants Infested by Meloidogyne javanica. Microorganisms 2020, 8, 1922. [Google Scholar] [CrossRef]
- Ciccarese, F.; Longo, O.; Ambrico, A.; Schiavone, D.; Ziadi, T. Use of Aphanocladium album (isolate MX-95) in control of grape rot diseases in pre- and post-harvest [Vitis vinifera L.; Apulia]. In Atti Delle Giornate Fitopatologiche (Italy) Vol. II, Riccione, Italy, 27–29 March 2006; FAO: Rome, Italy, 2008; pp. 443–447. [Google Scholar]
- Studer, M.; Flück, K.; Zimmermann, W. Production of chitinases by Aphanocladium album grown on crystalline and colloidal chitin. FEMS Microbiol. Lett. 1992, 99, 213–216. [Google Scholar] [CrossRef]
- Sivastava, A.K.; Défago, G.; Boiler, T. Secretion of chitinase by Aphanocladium album, a hyperparasite of wheat rust. Experientia 1985, 41, 1612–1613. [Google Scholar] [CrossRef]
- Palizi, P.; Goltapeh, E.M.; Pourjam, E.; Safaie, N. Potential of Oyster mushrooms for the biocontrol of sugar beet nematode (Heterodera schachtii). J. Plant Prot. Res. 2009, 49, 27–33. [Google Scholar] [CrossRef]
- Savoie, J.M.; Mata, G.; Mamoun, M. Variability in brown line formation and extracellular laccase production during interaction between white-rot basidiomycetes and Trichoderma harzianum biotype Th2. Mycologia 2001, 93, 243–248. [Google Scholar] [CrossRef]
- Yuen, T.K.; Hyde, K.D.; Hodgkiss, I.J. Interspecific Interactions among Tropical and Subtropical Freshwater Fungi. Microb. Ecol. 1999, 37, 257–262. [Google Scholar] [CrossRef] [PubMed]
- Morón-Ríos, A.; Gómez-Cornelio, S.; Ortega-Morales, B.O.; De la Rosa-García, S.; Partida-Martínez, L.P.; Quintana, P.; Alayón-Gamboa, A.; Cappello-García, S.; Gonzáles-Gómez, S. Interactions between abundant fungal species influence the fungal community assemblage on limestone. PLoS ONE 2017, 12, e0188443. [Google Scholar] [CrossRef]

| Strains | Collection Number | Acronym |
|---|---|---|
| Potential BCA | ||
| Aphanocladium album | DiSSPA AA MX-95 | MX95 |
| Pleurotus ostreatus | DiSSPA BA-ALPO | ALPO |
| Pleurotus eryngii | DiSSPA BA-AL142PE | AL142PE |
| Phytopathogens | ||
| Phytophthora nicotianae | DiSSPA 51P | PN |
| Sclerotinia sclerotiorum | DiSSPA 47S | SS |
| Sclerotinia minor | DiSSPA 9S | SM |
| Fusarium solani | DiSSPA 268F | FS |
| Fusarium oxysporum f. sp. lycopersici | DiSSPA 259F | FOL |
| Fusarium oxysporum f. sp. radicis-lycopersici | DiSSPA 267F | FORL |
| Athelia (Sclerotium) rolfsii | DiSSPA 20S | AR |
| Verticillium dahliae | DiSSPA 23V | VD |
| Index | Score | Definition of Mycelial Interaction |
|---|---|---|
| A | 1 | Deadlock 1 at mycelial contact |
| B | 2 | Deadlock at distance |
| C | 3 | Replacement 2 |
| CA1 | 3.5 | Partial replacement after an initial deadlock with mycelial contact |
| CA2 | 4.5 | Complete replacement after an initial deadlock with mycelial contact |
| CB1 | 4 | Partial replacement after an initial deadlock at a distance |
| CB2 | 5 | Complete replacement after an initial deadlock at a distance |
| Phytopathogenic Organisms | Antagonists (*) | ||
|---|---|---|---|
| MX95 | ALPO | AL142PE | |
| Phytophthora nicotianae | 56 a | 56 a | 56 a |
| Sclerotinia sclerotiorum | 96 b | 88 b | 88 b |
| Sclerotinia minor | 96 b | 88 b | 88 b |
| Fusarium solani | 104 c | 112 c | 112 c |
| Fusarium oxysporum f. sp. lycopersici | 104 c | 112 c | 104 c |
| Fusarium oxysporum f. sp. radicis-lycopersici | 104 c | 112 c | 112 c |
| Athelia rolfsii | 56 a | 56 a | 56 a |
| Verticillium dahliae | ∞ (**) d | 80 b | 80 b |
| Deadlock | Replacement of | ||||
|---|---|---|---|---|---|
| Antagonist vs. Pathogen | Pathogen vs. Antagonist | ||||
| Subtype | % | Subtype | % | Subtype | % |
| A | 25.0 | C | 25.0 | C | 20.8 |
| B | 4.2 | CA1 | 16.7 | CA2 | 8.3 |
| CA2 | 0 | ||||
| CB1 | 0 | ||||
| Total | 29.2 | 41.7 | 29.2 | ||
Publisher’s Note: MDPI stays neutral with regard to jurisdictional claims in published maps and institutional affiliations. |
© 2022 by the authors. Licensee MDPI, Basel, Switzerland. This article is an open access article distributed under the terms and conditions of the Creative Commons Attribution (CC BY) license (https://creativecommons.org/licenses/by/4.0/).
Share and Cite
D’Ambrosio, G.; Cariddi, C.; Mannerucci, F.; Bruno, G.L. In Vitro Screening of New Biological Limiters against Some of the Main Soil-Borne Phytopathogens. Sustainability 2022, 14, 2693. https://doi.org/10.3390/su14052693
D’Ambrosio G, Cariddi C, Mannerucci F, Bruno GL. In Vitro Screening of New Biological Limiters against Some of the Main Soil-Borne Phytopathogens. Sustainability. 2022; 14(5):2693. https://doi.org/10.3390/su14052693
Chicago/Turabian StyleD’Ambrosio, Giovanni, Corrado Cariddi, Francesco Mannerucci, and Giovanni Luigi Bruno. 2022. "In Vitro Screening of New Biological Limiters against Some of the Main Soil-Borne Phytopathogens" Sustainability 14, no. 5: 2693. https://doi.org/10.3390/su14052693
APA StyleD’Ambrosio, G., Cariddi, C., Mannerucci, F., & Bruno, G. L. (2022). In Vitro Screening of New Biological Limiters against Some of the Main Soil-Borne Phytopathogens. Sustainability, 14(5), 2693. https://doi.org/10.3390/su14052693

